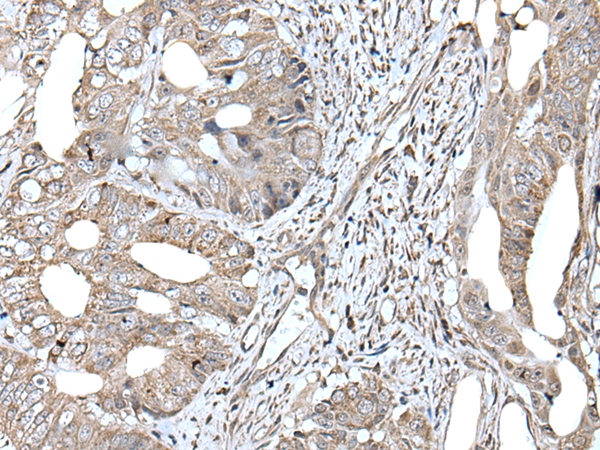

中文名稱: 兔抗RAD54B多克隆抗體
英文名稱: Anti-RAD54B rabbit polyclonal antibody
級(jí) 別: RDH54
相關(guān)類別: 一抗
抗 原: RAD54B
儲(chǔ) 存: 冷凍(-20℃)
宿 主: Rabbit
反應(yīng)種屬: Human
標(biāo) 記 物: Unconjugate
克隆類型: rabbit polyclonal
Background:
The protein encoded by this gene belongs to the DEAD-like helicase superfamily. It shares similarity with Saccharomyces cerevisiae RAD54 and RDH54, both of which are involved in homologous recombination and repair of DNA. This protein binds to double-stranded DNA, and displays ATPase activity in the presence of DNA. This gene is highly expressed in testis and spleen, which suggests active roles in meiotic and mitotic recombination. Homozygous mutations of this gene were observed in primary lymphoma and colon cancer.
Applications:
ELISA, IHC
Name of antibody:
RAD54B
Immunogen:
Synthetic peptide of human RAD54B
Full name:
RAD54 homolog B
Synonyms:
RDH54
SwissProt:
Q9Y620
ELISA Recommended dilution:
5000-10000
IHC positive control:
Human colorectal cancer
IHC Recommend dilution:
30-150
技術(shù)規(guī)格
購物車
幫助
021-54845833/15800441009
